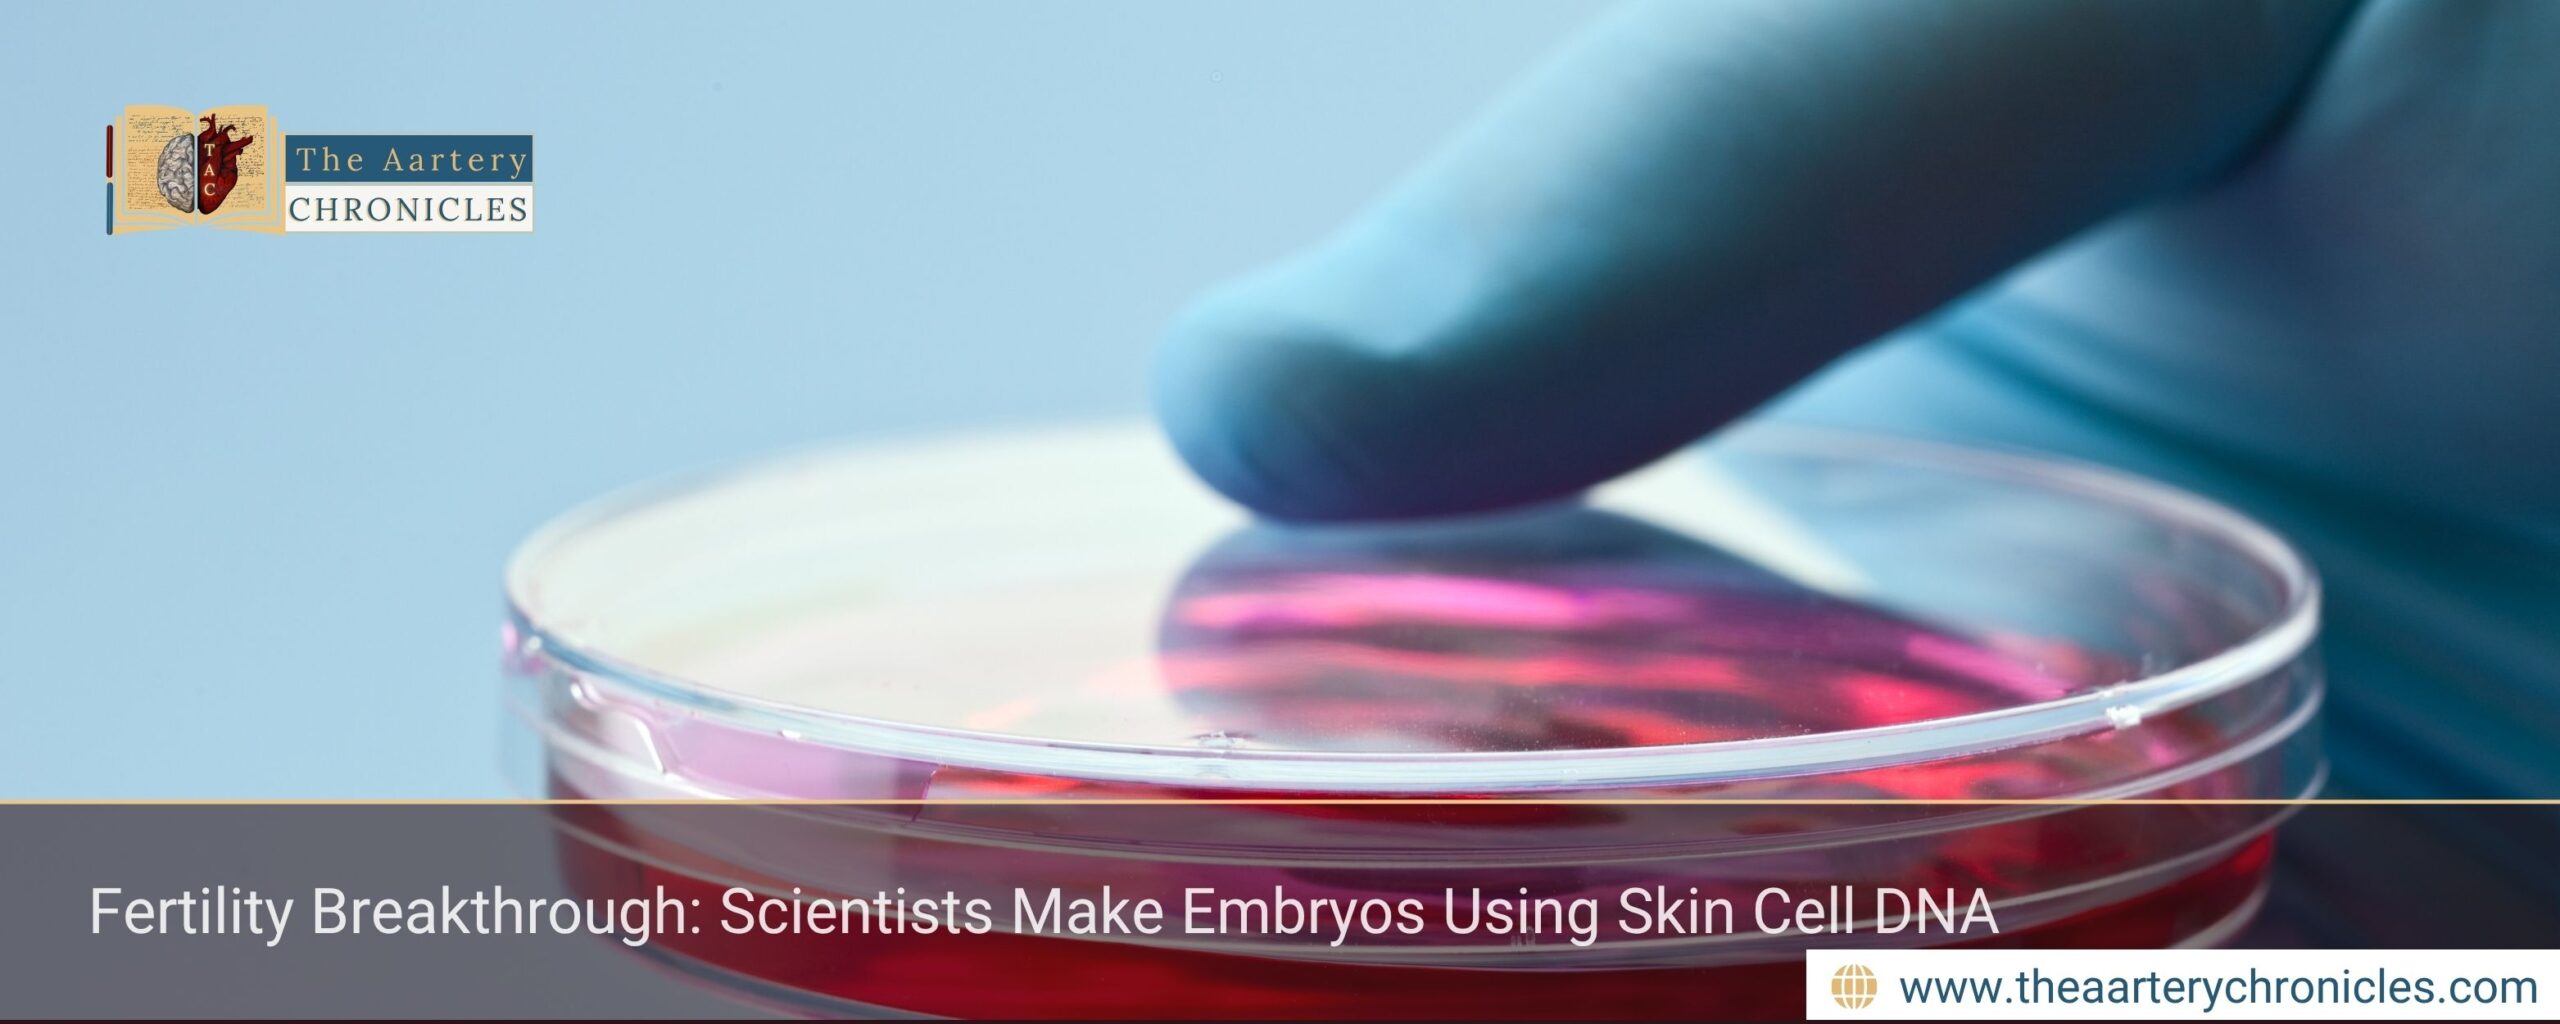

Fertility Breakthrough: Scientists Make Embryos Using Skin Cell DNA
Summary: Scientists have created early human embryos using DNA from skin cells and donor eggs. This breakthrough could help treat infertility and allow same-sex couples to have genetically related children.
Introduction
Scientists have made a major breakthrough in fertility research by creating early human embryos using DNA from skin cells and donor eggs. The technique could offer new hope to people struggling with infertility due to age, illness, or medical treatments. It may also allow same-sex couples to have children who are genetically related to both partners. Although still in the early stages, this discovery brings both remarkable possibilities and important ethical questions.
How the technique works
The nucleus containing the full genetic code is taken from a human skin cell.
This nucleus is transferred into an enucleated donor egg, with its own haploid genetic material removed.
The reconstructed egg is induced to undergo mitomeiosis, discarding half its chromosomes to mimic a natural egg.
Sperm is then introduced to fertilise the reprogrammed egg, restoring a complete set of 46 chromosomes.
The fertilised egg develops into an early-stage embryo.
What this breakthrough could mean
This technique is part of a growing field called in vitro gametogenesis, which explores how sperm and eggs can be created outside the body. Although it is still in the early stages, it offers hope for people who cannot use IVF because they do not have viable eggs or sperms. This includes older women whose eggs are no longer functional, men with low sperm counts, or people who became infertile due to cancer treatments.Â
The research also changes the way we think about parenthood. The skin cell used to create the egg does not have to come from a woman; it could come from a man instead. This opens the possibility for same-sex couples to have children who are genetically related to both partners. According to Professor Paula Amato from Oregon Health and Science University, the method could help millions of people with infertility and allow same-sex couples to share a biological connection with their child.
Building public trust
While the newly developed technique is a major breakthrough scientist also stress the importance of caution. Professor Roger Sturmey, from the University of Hull, said the research highlights the importance of maintaining open dialogue with the public and ensuring robust governance around such sensitive advances.
Looking Ahead
Also Read:Â AI Chip Detects Heart Attacks Faster Than Ever

Dane
I am an MBBS graduate and a dedicated medical writer with a strong passion for deep research and psychology. I enjoy breaking down complex medical topics into engaging, easy-to-understand content, aiming to educate and inspire readers by exploring the fascinating connection between health, science, and the human mind.